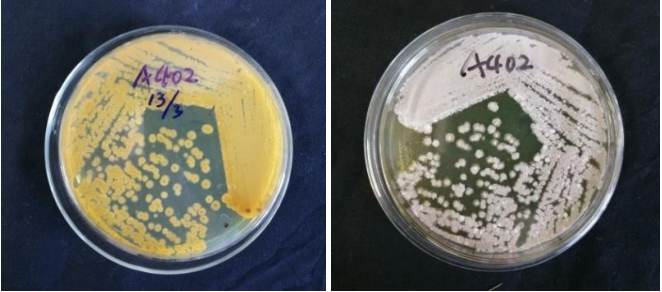

Loading...
| StrainNO | A402 |
| Classification | Streptomyces |
| 16s rDNA sequence | CCTGGCTCAGGACGAACGCTGGCGGCGTGCTTAACACATGCAAGTCGAACGATGAACCGGCTTCGGTCGGGGATTAGTGGCGAA CGGGTGAGTAACACGTGGGTGACCTGCCCCGCACTCTGGGATAAGCCTGGGAAACCGGGTCTAATACCGGATAGGACTCTCTGC CGCATGGTGGAGGGTGGAAAGCTTTTGTGGTGTGGGATGGGCCCGCGGCCTATCAGCTTGTTGGTGGGGTAGTGGCCTACCAAG GCGACGACGGGTAGCCGGCCTGAGAGGGTGTCCGGCCACACTGGGACTGAGACACGGCCCAGACTCCTACGGGAGGCAGCAGTG GGGAATATTGCACAATGGGCGGAAGCCTGATGCAGCGACGCCGCGTGAGGGATGACGGCCTTCGGGTTGTAAACCTCTTTCGAC AGGGAAGAAGCTTTCGGGTGACGGTACCTGTAGAAGAAGCACCGGCTAACTACGTGCCAGCAGCCGCGGTAATACGTAGGGTGC AAGCGTTGTCCGGAATTATTGGGCGTAAAGAGCTCGTAGGCGGCCTGTCGCGTCGGTTGTGAAAGCCCGGGGCTCAACCCCGGG TCTGCAGTCGATACGGGCAGGCTGGAGTTCGGCAGGGGAGACTGGAATTCCTGGTGTAGCGGTGAAATGCGCAGATATCAGGAG GAACACCGGTGGCGAAGGCGGGTCTCTGGGCCGATACTGACGCTGAGGAGCGAAAGCGTGGGGAGCGAACAGGATTAGATACCC TGGTAGTCCACGCTGTAAACGGTGGGCACTAGGTGTGGGCGGCATTCCACGTCGTCTGTGCCGTAGCTAACGCATTAAGTGCCC CGCCTGGGGAGTACGGCCGCAAGGCTAAAACTCAAAGGAATTGACGGGGGCCCGCACAAGCGGCGGAGCATGTGGCTTAATTCG ACGCAACGCGAAGAACCTTACCAAGGCTTGACATACGCCGGACACCTCCAGAGATGGGGGCTCCCTTTGGGCCGGTGTACAGGT GGTGCATGGCTGTCGTCAGCTCGTGTCGTGAGATGTTGGGTTAAGTCCCGCAACGAGCGCAACCCTTGTCCTGTGTTGCCAGCA CGCCCTTCGGGGTGGTGGGGACTCACGGGAGACTGCCGGGGTCAACTCGGAGGAAGGTGGGGATGACGTCAAGTCATCATGCCC CTTATGTCTTGGGCTGCACACGTGCTACAATGGCTGGTACAGTGGGCTGCGATGCCGTGAGGCGGAGCGAATCCCCAAAAGCCA GTCTCAGTTCGGATTGGGGTCTGCAACCCGACCCCATGAAGTCGGAGTCGCTAGTAATCGCAGATCAGCATTGCTGCGGTGAAT ACGTTCCCGGGCCTTGTACACACCGCCCGTCACGTCACGAAAGTCGGTAACACCCGAAGCCGGTGGCCTAACCACTCTGTGGGG GGAGCCGTCGAAGGTGGGACTGGCGATTGGGACGAAGTCGTAACAAGGTA |
| Strain Morphology Photos | |
| Morphological Description |